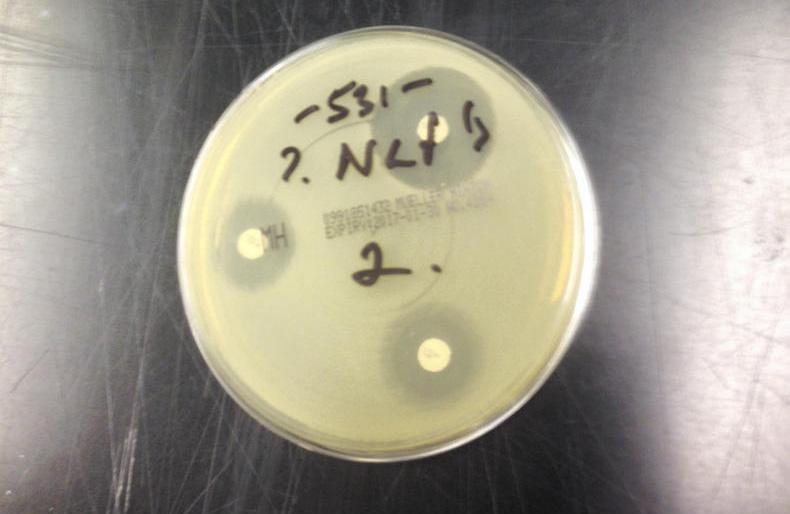

Superbugs, like most problems of global proportions, seem far away. This often means farmers brush over them to focus on more pressing issues. If it doesn’t affect "family, work or money most people won’t engage with issues" was the opinion of professor Martin Cormican of NUI Galway when he spoke at the Veterinary Ireland cattle conference (CAVI) last weekend.
Despite this, antibiotic resistance is fast becoming the medical challenge of the century. Most of the antibiotics humans use are the same as those given to farm animals (estimated to be at 85%).
The question still to be answered is how much of this resistance crosses between species.
Spreading
On farm, professor Cormican said he was concerned about salmonella and campylobacter infections becoming resistant and then spreading to humans.
He described scenarios around ESPL and MRSA infections, resistant strains of bacteria which can turn routine surgeries and infections into life-threatening conditions. He knows from experience that this is a very real problem.
Correct use
So, what can farmers and vets do?
"Make proactive decisions about your health and use antibiotics correctly and only when necessary," was his advice.
And of course, the simple but effective practise of washing your hands correctly was also highlighted.
Anyone working with other people or animals should learn how to wash and clean their hands correctly. Hygiene is so important in the prevention of spread of these bugs.
After talking to Martin, it hit home that we must endeavour to reduce our antibiotic usage on farm through good management and prevention strategies.
John had a sick weanling and was attempting to give her some leftover antibiotics when she kicked out, hitting him on the shin and shattering his tibia.
John spent the following week in hospital recovering. Surgery went well and he was sent home with strict instructions to rest and recuperate.
A week later John was back out in the yard limping around on a crutch with his leg wrapped in a bag.
On the second week post-surgery John started getting severe pains in his leg and feeling dizzy. He ignored these for as long as he could until it became unbearable. On a return to the hospital he was quickly diagnosed with septicaemia.
John was shocked as he'd taken all the antibiotics he'd been given.
The bacteria that is causing the infection was resistant to every antibiotic except one.
This infection seems to be susceptible to a fluoroquinolone, the doctor said (the same antibiotic John had injected his heifer with). The reality now for John was his life hung in the balance and depended on just one antibiotic to cure a simple but life-threatening infection.
With IV fluids and rigorous treatment, John made a slow recovery.
John had made many mistakes, not using his antibiotics properly like the doctor said.

SHARING OPTIONS